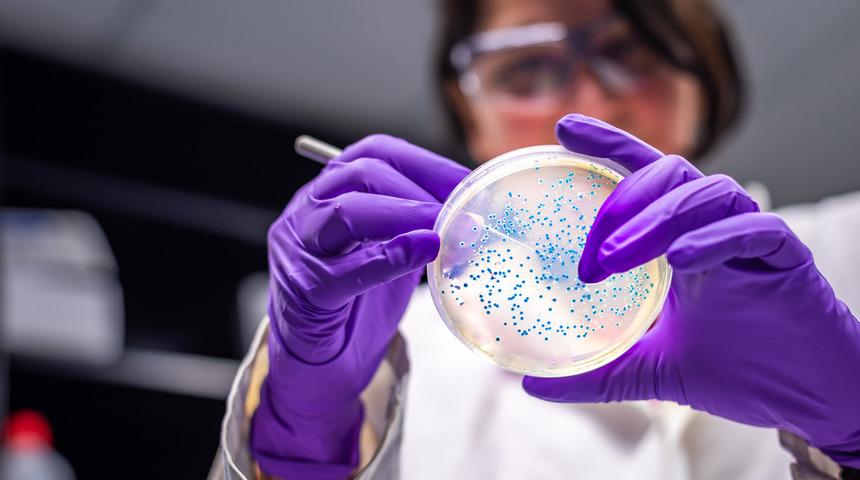
Salgın hastalık paniği büyüyor: Temas ile bulaşıyor, vaka sayısı giderek artıyor! Kaynağı tespit edilemedi

UKHSA'dan yapılan yazılı açıklamada, İngiltere, İskoçya, Galler ve Kuzey İrlanda'da koli basili bakterisinin neden olduğu hastalıklarda artış görüldüğü ifade edildi. Açıklamada, bakterinin kanlı ishal gibi ishal türleri ve idrar yolu enfeksiyonlarına neden olduğu belirtilirken, hastalıkların "e.coli" adı da verilen bakteriyi taşıyan gıdalara, hastalığın bulaştığı kişi ve hayvanlarla temas sonucu ortaya çıktığı vurgulandı.
Ülkede bir salgın bulunduğu ifade edilen açıklamada vakaların geniş bir bölgede görülmesinin nedeni olarak ulusal çapta dağıtımı yapılan gıdaların ön plana çıktığı belirtildi. Açıklamada bulaş kaynağının tespit edilemediğine ve çiftlikler, içme suyu, havuzlar, deniz suyu, göller ya da nehirler olduğu yönünde bir kanıt bulunmadığına da işaret edildi.

Birleşik Krallık genelinde 4 Haziran itibariyle 113 vaka tespit edildiği ifade edilen açıklamada, bunun 81'inin İngiltere'de, 18'inin Galler'de, 13'ünün İskoçya'da görüldüğü kaydedildi. Açıklamada, bir vakanın ise Kuzey İrlanda'da tespit edildiği ancak bu kişinin İngiltere'yi ziyaret geçmişi bulunduğu belirtildi.

Koli basili tespit edilenlerin en küçüğünün 2, en yaşlısının ise 79 yaşında olduğu aktarılan açıklamada, yıl sonuna kadar vaka sayısının 1500'e çıkabileceğinin tahmin edildiği bildirildi.
Açıklamaya göre, İngiltere'de görülen 81 vakanın yüzde 60'ı hastanede tedavi altına alınırken 61 kişi bulaş kaynağı olabilecek gıda ve seyahat bilgisi paylaştı.

Salgının önüne geçilebilmesi için ellerin sık sık sabun ve ılık suyla yıkanması, gıda hijyen önlemlerine uyulması, meyve ve sebzelerin iyice yıkanarak pişirilmesi, ishalken başkalarıyla temasın kesilmesi ve mümkünse okul ve işe gidilmemesi tavsiye edildi.

Açıklamada değerlendirmelerine yer verilen UKHSA Vaka Yöneticisi Trish Mannes, koli basilinin ishalin yanı sıra mide krampları, kusma ve ateşe neden olduğunu söyledi. Mannes, ishal ve kusma şikayetleri olan kişilerin başkalarına yemek hazırlamaması gerektiğini belirterek, "Semptomlarınız geçtikten 48 saat sonrasına kadar okula, işe ya da kreşe dönmeyin." uyarısında bulundu.

İngiltere Gıda Standartları Kurumundan Daren Whitby de salgın kaynağının bir ya da birden fazla gıda ürünü olabileceği üzerinde durduklarını ifade etti. Whitby, gıda satın almaktan hazırlamaya kadar dikkatli olmak gerektiğinin altını çizerek, "Elleri, yemek yapımında kullanılan ekipmanları, mutfak eşyalarını ve yüzeyleri iyice temizlemek çapraz bulaşmayı da engeller." dedi.

Açıklamada, 1 yaş altı bebekler, sütten kesilen çocuklar, uzun süre idrar yapmayan 5 yaş altı çocuklar ile 7 günden uzun ishal ve 2 günden uzun kusma şikayeti olanların bir an önce sağlık kuruluşlarıyla temasa geçmeleri önerildi. (AA)